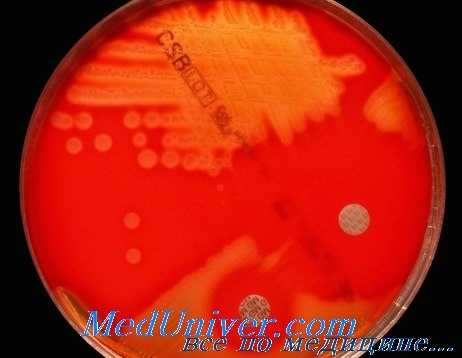

Инфекции гемолитических стрептококков: диагностика, лечение, профилактика
Добавил пользователь Дмитрий К. Обновлено: 16.01.2026
Стрептококковые инфекции вызванные Streptococcus pyogenes: диагностика, лечение, профилактика
Стрептококки — грамположительные кокки, располагающиеся в микропрепарате в виде цепочки или парами. Факультативные анаэробы требовательны к питательным средам. Хорошо растут на средах с большим содержанием крови. Колонии бета-гемолитического стрептококка на кровяном агаре окружены зоной полного гемолиза, а-гемолитического стрептококка — зоной частичного гемолиза.
Дальнейшая идентификация основана на изучении биохимических и серологических (классификация Лэнсфилд) свойств возбудителя. Исследуемый материал — мазок из зева, раневое отделяемое, кровь и др.
Стрептококковые инфекции вызванные Streptococcus pyogenes
Носительство в глотке S. pyogenes протекает бессимптомно примерно у 5—30% населения. Передача инфекции осуществляется посредством аэрозольного и контактного механизмов. Заражение может произойти в любом возрасте, но чаще всего инфекция возникает у детей.

Патогенез стрептококковых инфекций вызванных Streptococcus pyogenes
S. pyogenes имеет углеводный (полисахаридный) группоспецифический антиген А (антиген Лэнсфилд) и группоспецифический белковый М-антиген, и располагающиеся на поверхности микроорганизма М-протеином (антиген), препятствующий лейкоцитарному фагоцитозу.
Антитела к М-протеину и располагающимся на поверхности микроорганизма М-протеину (антиген) формируют устойчивый иммунитет к последующей инфекции, вызванной микроорганизмами с такими же типами М-протеина. Кроме того, S. pyogenes продуцируют несколько токсинов: эритрогенный токсин (вызывает сыпь при скарлатине) и пирогенные экзотоксины А, В и С. Адгезию обеспечивают рецепторы к фибронектину.
Возбудители способны долгое время персистировать внутри клеток эпителия зева, а потому некоторые антибиотики (не проникающие внутриклеточно) не избавляют пациента от носительства.
Клинические признаки стрептококковых инфекций вызванных Streptococcus pyogenes
S. pyogenes входит в число десяти самых смертоносных возбудителей в мире. Он вызывает три вида патологических состояний:
• Инфекционное заболевание. S. pyogenes — самая частая причина развития бактериального фарингита. Кроме того, он вызывает рожу, импетиго, целлюлит, раневые инфекции и реже некротизирующий фасцит и пневмонию. Иногда развивается септицемия, приводящая к метастазирующим инфекциям (остеомиелит). Инфекционный процесс, обусловленный S. pyogenes, характеризуется острым началом с деструкцией поражённых тканей и быстро прогрессирующим течением.
Неотъемлемой частью патогенеза, развивающегося выраженного интоксикационного синдрома, является способность S. pyogenes продуцировать токсины.
• Токсин — индуцированные синдромы, протекающие на фоне инфекционного заболевания. Инфекционное заболевание, связанное с S. pyogenes, может протекать в виде генерализованного процесса или, оставаясь локализованным, сопровождаться системными проявлениями, связанными с действием экзотоксинов.
Например, действие эритрогенного токсина обусловливает возникновение сыпи при скарлатине, а пирогенные токсины становятся причиной стрептококкового шока, часто приводящего к смерти пациента вследствие полиорганной патологии. • Постинфекционные аутоиммунные заболевания. Перекрёстное взаимодействие антител к антигенам бактерии и структурным компонентам собственных тканей организма иногда приводит к развитию аутоиммунных заболеваний: ревматической лихорадке, гломерулонефриту или узловатой эритеме.
Достаточно редкая в странах с развитой рыночной экономикой ревматическая лихорадка — частая причина смерти и инвалидизации населения в регионах с низким уровнем жизни и нищетой.
Профилактика стрептококковых инфекций вызванных Streptococcus pyogenes
Распространение S. pyogenes в хирургических отделениях и родильных домах происходит достаточно быстро. Именно поэтому больных и носителей стрептококковой инфекции нужно немедленно изолировать в отдельные боксы на срок не менее 48 ч от начала проведения эффективной антибиотикотерапии. Своевременное полноценное лечение позволяет избежать развития вторичных аутоиммунных заболеваний (ревматическая лихорадка).
Редактор: Искандер Милевски. Дата обновления публикации: 18.3.2021
Инфекции гемолитических стрептококков: диагностика, лечение, профилактика
Микробиологическая диагностика стрептококка. Диагностика стрептококковой инфекции. Выявление стрептококка. Выделение стрептококка.
Основу микробиологической диагностики стрептококковой инфекции составляют выделение и идентификация возбудителя. При этом обычно биохимические характеристики изолятов не изучают. Прочие методы диагностики стрептококковой инфекции имеют различные ограничения.
Через 24 ч на КА стрептококки группы А образуют блестящие вязкие колонии (рис. 2, см. цветную вклейку). В жидких средах бактерии дают придонный, иногда поднимающийся вверх рост. Весьма информативные методы раннего выявления стрептококков — определение чувствительности к антимикробным агентам методом дисков.
Наиболее часто их используют для идентификации стрептококков в мазках из зева. Для дифференцировки стрептококков группы А от прочих b-гемолитических стрептококков применяют тест чувствительности к бацитрацину. Более чем в 99% случаев изоляты стрептококков группы А чувствительны к бацитрацину, тогда как представители других серогрупп обычно устойчивы (рис. 12-8). Также можно применить тест чувствительности к триметоприм-сульфаметоксазолу.

Стрептококки групп А и В обычно чувствительны к действию антимикробного агента.
По сравнению с чувствительностью к бацитрацину более специфичен тест гидролиза пиррол идонил-b-нафтиламида (ПИР-тест). S. pyogenes — единственный стрептококк, дающий положительную реакцию. Для этого в пробирки вносят полоски фильтровальной бумаги, пропитанные ПИР. Под действием бактериальных пептидаз ПИР расщепляется до b-нафтиламида, и после внесения 0,01% раствора p-диметиламиноциннамальальдегида полоски окрашиваются в вишнёво-красный цвет.
Стрептококки группы А легко можно выявить в мазках из зева, используя коммерческие наборы; групповой А-Аг экстрагируют химическими реагентами или ферментами и идентифицируют в реакциях латекс-агглютинации, коагглютинации или ИФА. Для экспресс-диагностики ревматического процесса и гломерулонефрита можно определять AT к стрептолизину О или стрептодорназе; серологические исследования также позволяют выявить носителей. Следует помнить, что AT к стрептолизину О не образуются при кожных инфекциях, вызываемых стрептококками группы А.
Лечение стрептококковой инфекции
Основу лечения стрептококковой инфекции составляет адекватная антибактериальная химиотерапия. Лечение ревматизма проводят пенициллинами короткого действия, профилактику — пенициллинами длительного действия (бициллин-5), причём антибиотикопрофилактику предпочтительно проводить круглогодично.
Информация на сайте подлежит консультации лечащим врачом и не заменяет очной консультации с ним.
См. подробнее в пользовательском соглашении.
Стрептококковая инфекция: диагностика и лечение
У каждого инфекционного заболевания есть возбудители — патогенные или условно-патогенные микроорганизмы. Первые вторгаются в организм извне, вторые принадлежат к малочисленной части естественной микрофлоры и активизируются только при благоприятных для размножения условиях.
Этиологию инфекции определяют по ее принадлежности к группе — вирусам, бактериям, протозойным микроорганизмам, грибкам, глистам или простейшим паразитам. Среди большого количества бактерий к категории особо опасных относятся стрептококки. Они провоцируют тяжелые патологии — вплоть до токсического шока с высокой вероятностью летального исхода. Об особенностях стрептококковой инфекции, методах лечения и профилактики расскажем в статье.
Стрептококковые инфекции
Источник инфекции — зараженный ребенок или взрослый. Пути передачи стрептококка:
- аэрогенный — во время близкого общения с больным человеком, включая бессимптомное носительство инфекции;
- пищевой — через зараженную еду — молочные, кисломолочные продукты;
- контактно-бытовой — через предметы, обсемененные бактериями;
- интранатальный — если половая система женщины поражена стрептококковой инфекцией.
Из-за высокой контагиозности возбудителей существует риск эпидемии среди социально-организованных детей.
Классификация стрептококков
Streptococcus — грамположительные бактерии факультативно-аэробного вида. В мизерном количестве они обитают на коже, в ЖКТ, на слизистых рта и органов мочеполовой системы. Бактериальное семейство насчитывает 83 представителя. Причинно-значимыми являются:
- A-гемолитический Streptococcus — вызывает гнойные инфекции, воспалительные патологии сердца, пневмококковую пневмонию.
- B-гемолитический Streptococcus — включает пять групп опасных возбудителей (A, B,C, D, F, G). Самым активным считается Streptococcus pyogenes группы А, провоцирующий болезни ЛОР-органов, дыхательной системы, острые воспаления сердца, почек, тяжело излечимые поражения кожи.
Бактерии достаточно устойчивы к факторам окружающей среды. Они выдерживают температуру до 60℃, в течение четверти часа способны противостоять антисептикам, санитайзерам. В засохшей мокроте, гное сохраняют жизнеспособность в течение нескольких месяцев.
Факторы вирулентности
Стрептококкам свойственна высокая вирулентность — способность быстро захватить и погубить атакованный организм. Основными факторами служат умения микроорганизмов:
- оперативно колонизироваться и диссеминировать;
- обходить иммунную защиту;
- мгновенно связываться со специфическими рецепторами для вхождения в клетки организма.
Патогены вырабатывают вещества, разрушающие ткани, а также экзотоксины, которые провоцируют развитие цитокинового шторма. Это главная причина токсического шока и летального исхода. Проникая через слизистые ротоглотки или повреждения на коже, возбудитель образует бактериально-активный очаг, в который включается и условно-патогенная микрофлора. Стрептококки выделяют в кровь ядовитые вещества, вызывающие системный иммунный ответ — выброс цитокинов, гистамина, синтез иммуноглобулинов. При значительной бактериальной нагрузке, ослабленном иммунитете организм не может дать возбудителю достойный отпор. Течение болезни может быть крайне тяжелым, лечение — длительным, а риск постинфекционных осложнений — высоким.
Болезни, вызываемые стрептококками
Активный β-гемолитический Streptococcus группы А вызывает болезни с разной симптоматикой и течением. Клиническая картина стрептококковой инфекции зависит от локализации воспалительного очага, бактериальной нагрузки, преморбидного фона пациента. Из-за «живучести» достаточно сложно подобрать эффективное лекарство от инфекционного заболевания.
Стрептококковый фарингит
Воспаление локализуется на задней стенке глотки — в слизистой оболочке. Инкубационный период длится 2-3 дня, затем появляются острые симптомы — боль при проглатывании слюны, увеличение и болезненность шейных лимфоузлов, гипертермия. Примерно у 20% пациентов в инфекционный процесс вовлекается лимфаденоидная ткань миндалин, развивается фаринготонзиллит. Болезнь характеризуется высокой температурой, образованием серозно-гнойных пробок на слизистой миндалин, нестерпимой болью в горле. Осложнением может стать паратонзиллярный абсцесс.
Скарлатина
Острое воспаление ротоглотки часто диагностируется у детей дошкольного возраста. Скарлатина дебютирует высокой температурой, признаками интоксикации организма. Характерные симптомы — отекший ярко-малиновый язык, мелкоточечные папулезные высыпания, локализующиеся преимущественно на лице и верхней части тела. При легких формах болезни разрешено амбулаторное лечение. Маленьких детей госпитализируют из-за риска гнойно-воспалительных осложнений.
Инфекции кожи
У детей часто встречается стрептодермия, у взрослых — рожистое воспаление или стрептококковая флегмона. Первые признаки стрептодермии — кожные фликтены, наполненные серозной жидкостью. Они трансформируются в гнойные пузырьки, после которых на коже образуются плотные корочки. Дети часто расчесывают зудящие высыпания, перенося стрептококк на здоровые участки кожного покрова, из-за чего лечение усложняется. Ускорить выздоровление помогает принудительное вскрытие фликтен с последующей обработкой кожи Фукорцином, антибактериальными мазями.
Рожистое воспаление — поверхностное воспаление кожи, флегмона — глубокое воспалительное поражение, распространяющееся на подкожно-жировую клетчатку. Заболевания сопряжены с головной болью, лихорадкой, бессонницей, регионарным лимфаденитом.
Некротизирующий фасциит
Гнойное воспаление соединительной ткани, сопряженное с отмиранием клеток кожи и подкожно-жирового слоя на пораженном участке. Характеризуется высокой скоростью развития, тяжестью течения, частыми осложнениями, рисками летальности. Патогенез тесно связан с тромбозом сосудов, из-за которого возникает дефицит кислорода, поступающего к мягким тканям.
Синдром токсического шока (СТШ)
Большая часть случаев СТШ связна с применением суперабсорбирующих гигиенических тампонов во время месячных. Крайне тяжелое соматическое состояние вызывается гиперцитокинемией — перепроизводством цитокинов в ответ на поражение организма токсинами стрептококков. Это приводит к разрыву информационных связей между Т-лимфоцитами, в результате чего они атакуют клетки собственного организма. Резко увеличивается проницаемость сосудов, падает давление, межклеточное пространство заполняется плазмой, развивается полиорганная недостаточность. Страдают легкие, сердце, затем отказывают почки, печень.
Поздние осложнения
Механизм развития поздних осложнений не изучен. К основным патологиям относятся гломерулонефрит, сепсис, некротический миозит, ревматическая лихорадка.
Диагностика
Идентифицировать возбудителя активной формы болезни или выявить носительство инфекции можно с помощью лабораторных исследований биоматериала (соскоба с кожи, мазка из горла). Для диагностики применяют бактериологический посев. При обнаружении колоний стрептококка дополнительно выполняют антибиотикограмму — определение резистентности к разным видам антибиотиков.
Лечение
Препараты для этиотропной терапии детям и взрослым подбирают по результатам лабораторной диагностики. Многие бактерии гемолитического стрептококка проявляют чувствительность к антибиотикам пенициллиновой группы. При неэффективности лечения пенициллины заменяют макролидами — Сумамедом, Азитромицином, Кларитромицином. Для предотвращения дисбаланса микрофлоры параллельно назначают пробиотики и пребиотики. Дополнительно проводят лечение симптомов исходя из клинической картины заболевания. Из современных препаратов рекомендуется использовать Бактериофаг стрептококковый — раствор для орошений слизистых, аппликаций, клизм, спринцевания.
Читайте также:
